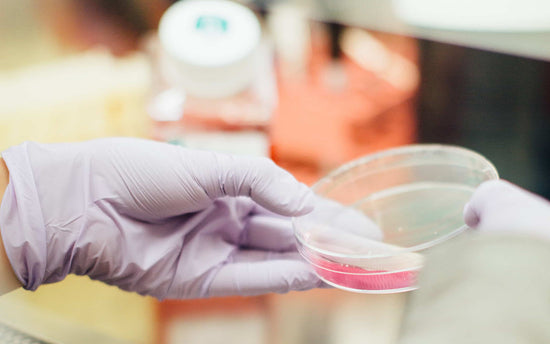

Enestående sundhedsløsninger - til at opnå dit fulde potentiale!
-

Vores filosofi
NovoVita® er skabt ud fra et stærkt ønske om at udvikle rene, aktive og ærlige produkter, der tilfører kroppen de livsvigtige næringsstoffer, som kan mangle i en gennemsnitlig, vestlige diæt.
Vores produkter adskiller sig fra andre på markedet ved at være baseret på nøje udvalgte, rene og let-optagelige ingredienser. Vores produkter tager samtidig udgangspunkt i den nyeste sundhedsforskning, som vores diætist og ernæringseksperter er opdateret omkring.
Det betyder at vores kunder er garanteret produkter af høj kvalitet med en signifikant effekt på kroppens sundhed. -

Aktive ingredienser
Vitaminer og mineraler fås i mange forskellige former. Hos NovoVita® er vores mål altid at bruge den form, der er nemmest for kroppen at optage. Sådan får vores kunder mest muligt ud af NovoVita® unikke produkter.
Valget af specifikke aktive stoffer, styrken af disse, samt deres forhold til hinanden, afgør effektiviteten af et kosttilskud. NovoVita® produktformularer er derfor udviklet på baggrund af den nyeste sundhedsforskning og med en målsætning om produkter, der har optimal virkning på kroppen. -

Renhed
Vi går ind for renhed i vores produkter og bruger derfor ikke flere ingredienser, fyldemidler eller bindemidler end højest nødvendigt. Hvis tilsætningsstoffer er påkrævet, bruger vi KUN naturlige tilsætningsstoffer såsom rismel.
Vi har også valgt at vores produkter kun skal bestå af pulver og kapsler, da tabletter kan indeholde op til 85% hjælpestoffer. -

Høj kvalitet
Råvarerne er lige så afgørende for et præparats kvalitet, som formularen. Derfor er der for hver af de rå ingredienser i vores produkter udført et uafhængigt analyse-certifikat, der attesterer råvarens kvalitet og renhed.
Hvor det er muligt bruger vi økologiske eller food-based ingredienser. NovoVita® produkter er udviklet i Danmark og produceret i EU under strenge kvalitetskrav. Vores produkter og producenter har opnået følgene certifikater: